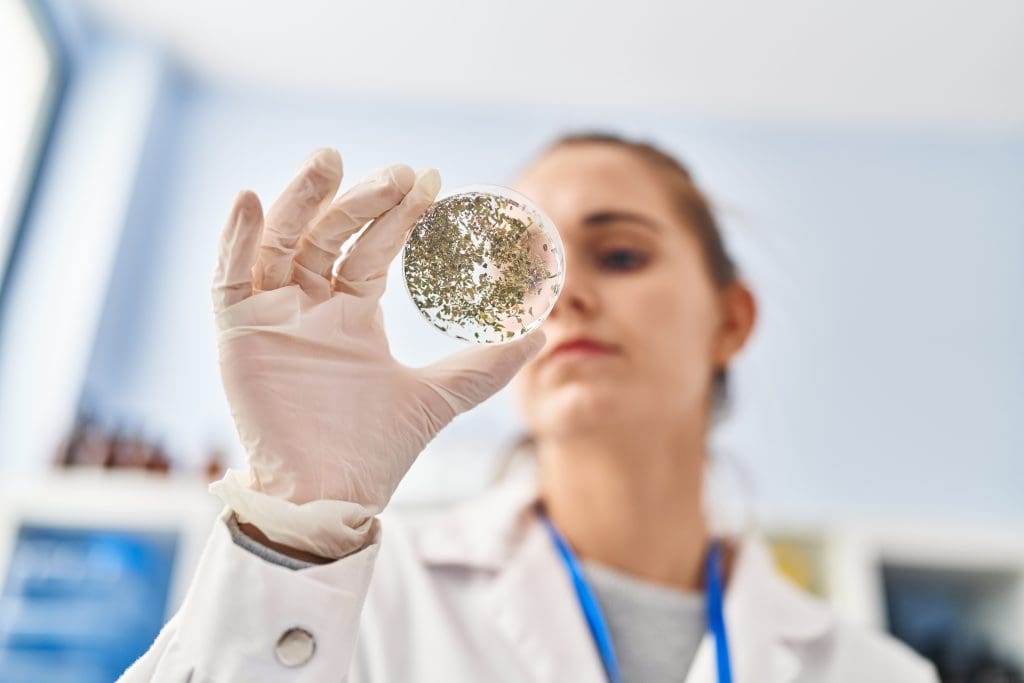
The Controversial Embryonic Stem Cell Ban Explained 2 young blonde woman wearing scientist uniform looking sample laboratory LIV Hospital

The use of embryonic stem cells has sparked a lot of debate. This debate centers on their research and use. A surprising fact is that U.S. politics, not scientific evidence, has fueled this controversy.
This situation creates a complex environment. It pits the benefits of stem cell research against ethical worries. To understand why stem cells are so debated, we must look at the historical and political backdrop.
Embryonic stem cells can grow into almost any cell in the body. They come from embryos and can turn into different cell types. This makes them very useful for medical research and possible treatments.
These cells come from the inner part of a blastocyst, an early embryo. They can keep growing and stay able to become any cell type in the body.
Embryonic stem cells can turn into any of the three main cell layers: ectoderm, endoderm, and mesoderm. This makes them great for fixing or replacing damaged tissues. Pluripotent stem cells can become specific cell types with the right conditions. This opens up new possibilities for fixing damaged tissues.

Unlike adult stem cells, embryonic stem cells can do more. Adult stem cells can only turn into certain cell types and are found in specific tissues. The table below shows the main differences between embryonic and adult stem cells.
| Characteristics | Embryonic Stem Cells | Adult Stem Cells |
| Differentiation Ability | Pluripotent, can form any cell type | Multipotent, limited to specific cell types |
| Source | Derived from embryos | Found in adult tissues |
| Self-Renewal | High capacity for self-renewal | Limited self-renewal capacity |
Knowing these differences helps us see the good and bad sides of using embryonic stem cells in medicine.

The journey of stem cell research has been complex. It has been shaped by scientific breakthroughs and societal debates. From the first isolation of embryonic stem cells, the field has made great strides.
In the early 1960s, the idea of stem cells started to form. Later, in 1998, the first human embryonic stem cells were isolated by a research team. This was a major turning point in stem cell research.
Important milestones include the ability to grow and change embryonic stem cells. These achievements have opened new ways to study human development and disease.
As stem cell research grew, ethical issues came up. The debate over the moral status of embryos has been at the heart of the controversy.
Despite these challenges, the field keeps moving forward. An expert in the field stated “The promise of stem cell research is vast, with new hope for treating many diseases.”
“The promise of stem cell research is vast, with new hope for treating many diseases.”
Embryonic stem cells are key in regenerative medicine, bringing hope for chronic disease cures. They can turn into many cell types, making them very useful for medical research and treatment.

Regenerative medicine aims to fix or replace damaged tissues and organs. These stem cells can become specific cell types. This could help treat heart disease and spinal cord injuries.
Key Applications:
Embryonic stem cells can model diseases in a lab. This lets researchers study how diseases progress and test treatments. It’s very helpful for understanding complex diseases like Alzheimer’s.
“The ability to model human diseases using embryonic stem cells has revolutionized our understanding of disease mechanisms and opened new avenues for drug discovery.” – A Stem Cell Researcher
Chronic diseases, like diabetes and arthritis, could be treated with stem cell therapies. These stem cells can turn into the right cell types. This could help restore function and ease symptoms.
| Disease | Therapeutic Potential |
| Diabetes | Insulin-producing beta cells |
| Arthritis | Cartilage regeneration |
| Heart Failure | Cardiac tissue repair |
The uses of embryonic stem cells in therapy are wide and promising. They offer new hope for treating chronic diseases through regenerative medicine and cell therapy.

Using embryonic stem cells in research raises many ethical questions. These debates are happening all over the world. At the center is the moral status of human embryos and the balance between medical benefits and ethical worries.
Is it right to treat human embryos the same as fully grown humans? Some believe embryos have inherent dignity and should be protected. Others think they have the chance to become people but aren’t yet.
When does human life start? People have different views, from the moment of conception to when certain features develop. This disagreement makes the debate on embryonic stem cell research even more complex.
Supporters of using embryos in research say it could lead to finding cures for serious diseases. But, critics argue that destroying embryos, even in the early stages, is not worth it. Below is a table that outlines some of the main points on both sides.
| Perspective | Arguments For | Arguments Against |
| Medical Benefits | Potential cures for diseases | Destruction of human embryos |
| Ethical Concerns | Embryos are not yet persons | Embryos have moral status |
The main ethical issue is finding a way to advance medicine while respecting human life at all stages. As research goes on, it’s a big challenge to find a solution that everyone can agree on.
The debate over stem cell research is fueled by several factors. These include the destruction of human embryos and worries about treating human life as a commodity. At the core of the controversy are ethical dilemmas. They challenge the balance between advancing medical science and respecting human dignity.
One major concern is the destruction of human embryos in embryonic stem cell research. Critics say that getting stem cells from embryos kills off possible human life. This raises big moral and ethical questions. Supporters, on the other hand, believe the benefits of this research, like creating life-saving treatments, are worth it.
The debate centers on the moral status of human embryos. Some think embryos have the same moral value as fully grown humans. Others believe they are not yet fully human and can be used for research.
Another worry is the possibility of treating human life as a commodity. Using human embryos for research makes some fear that life could be seen as something to be used for science or money. This fear grows when human embryos are made just for research, not from IVF treatments.
Key concerns include:
Consent and donation are also big issues. Using embryos for research needs donors’ consent. But, there are doubts about how well donors understand what they’re agreeing to. There’s also worry about coercion or unfair pressure in the donation process.
To tackle these issues, many countries have set rules for using human embryos in research. These rules include needing informed consent and strict checks.
Religious views on embryonic stem cell research are diverse. Each faith has its own take on the ethics of this science.
The Catholic Church strongly opposes embryonic stem cell research. They believe life starts at conception and destroying embryos is like taking a human life. This belief is based on the Church’s teachings on human life’s sanctity.
Protestants have different opinions on this topic. Some see it as a chance for medical progress and helping people. Others, like the Catholic Church, worry about the embryos’ destruction.
In Judaism, the debate is about the embryo’s moral status. Some say embryos outside the womb might not have the same moral value. Islamic views also vary, with some allowing research before a certain stage, based on Islamic law.
Other faiths, like Hinduism and Buddhism, also have unique views. For example, some Buddhist scholars support research for its medical benefits. They focus on compassion and reducing suffering.
The wide range of religious views on embryonic stem cell research shows how complex the issue is. It’s important to understand these perspectives to have a full discussion.
To understand the legal status of embryonic stem cells, we need to look at both federal and state laws. The rules are made up of federal rules, state laws, and changes over time.
Federal laws are key in controlling stem cell research. The Dickey-Wicker Amendment, passed in 1996, stops federal money for research that harms human embryos. This rule has been renewed every year, greatly affecting stem cell research.
Executive orders have also shaped the law. For example, President George W. Bush’s 2001 order only allowed funding for certain research lines before August 9, 2001.
State laws differ a lot in the U.S. Some places, like California and New York, support and fund stem cell research more than federal laws do. But, other states have banned or restricted it.
This mix of laws makes it hard for researchers. They often have to follow different rules based on where they work.
There have been big changes in stem cell research laws over time. A key change was in 2009. President Barack Obama’s order lifted the Bush-era limits, allowing more federal funding for research.
These changes show the ongoing debate and how the laws keep changing in the U.S.
The current rules for embryonic stem cells in the U.S. come from federal laws, state policies, and past changes. As research grows, the laws will likely change too.
In 2001, President Bush made a big change in stem cell research. This move sparked a lot of debate on ethics, science, and politics.
On August 9, 2001, President Bush signed an executive order. It allowed funding for research on stem cells already created. But, it stopped funding for new stem cell lines after that date. This limited what research could be done with government money.
The Bush policy only funded stem cell lines made before August 9, 2001. This made it hard to find stem cells for research. Many lines were not good for study because of mouse cell contamination.
The Bush ban slowed down stem cell research in the U.S. Many scientists had to find private money or work abroad. This led to a loss of talent in the field.
Also, the ban made it hard to move research to clinical trials. Researchers lacked the funds needed for this step.
In 2009, President Obama made a big change for stem cell research. He did this through an executive order. This order let more embryonic stem cell research get federal funding.
On March 9, 2009, Obama signed Executive Order 13505. It removed old rules on funding for human embryonic stem cell research. This was a big win for scientists, opening up new ways to use these cells for health.
The new rules let researchers do more studies with embryonic stem cells. This could lead to big advances in medicine and understanding human growth. It was a key step forward for science.
Even with the new rules, some limits stayed in place. Federal money couldn’t be used for making human embryos for research. Or for putting human stem cells into animals. These rules show the ongoing debate on stem cell ethics.
The rules for using embryonic stem cells vary worldwide. Each country has its own way of handling this research. This shows the different views on ethics, culture, and science.
The European Union has rules for using embryonic stem cells. But, each country in the EU has its own rules. Some are more open, while others are stricter.
In Asia, like China, Japan, and South Korea, stem cell research is big. But, their rules are different. Some are more open to it.
Key differences include:
These global differences make working together hard. Some places have strict rules, while others are more relaxed.
It’s important for researchers and leaders to understand these differences.
Embryonic stem cell research is key for scientists around the world. These cells can turn into almost any cell type. This makes them very useful for fixing damaged tissues.
This research could lead to big medical wins. It might help treat diseases like Parkinson’s, diabetes, and spinal cord injuries. This is because it can create new cells and tissues for transplants.
Those who support this research say the embryos are extra from IVF. They would be thrown away if not used. They see using these embryos as a way to help people, not harm them.
The ethics of using embryos for research are tricky. People disagree on when life starts and the rightness of using embryos for science.
Many IVF embryos are not used and are set to be thrown away. Supporters say using them for research is better than just getting rid of them. It could lead to major medical discoveries.
In summary, there are many reasons to support embryonic stem cell research. They include the chance for new medical treatments and the ethics of using embryos. As research moves forward, the case for using these cells will likely get stronger.
Embryonic stem cell research is met with opposition due to ethical, moral, and scientific concerns. The debate is complex, involving many perspectives and stakeholders.
One major argument against this research is the sanctity of life. It suggests that life starts at conception. Destroying embryos for research is seen as morally wrong, like taking a human life. Supporters argue that the benefits of stem cell research don’t outweigh the loss of human embryos.
Another worry is the slippery slope. Allowing this research might lead to more ethical issues. Critics fear it could open the door to practices like human cloning or creating human-animal hybrids.
Those against embryonic stem cell research suggest looking at other options. For example, induced pluripotent stem cells (iPSCs) are made from adult cells. Research on adult stem cells and umbilical cord blood stem cells also avoids the ethical problems of embryonic stem cells.
| Concerns | Description | Alternative Solutions |
| Sanctity of Life | Destruction of human embryos is considered morally wrong. | Use of adult stem cells or iPSCs. |
| Slippery Slope | Fear of progressing to more ethically controversial practices. | Strict regulation and ethical oversight. |
| Alternative Paths | Avoidance of ethical dilemmas associated with embryonic stem cells. | Research on iPSCs, adult stem cells, and umbilical cord blood stem cells. |
The debate over embryonic stem cell research is complex, touching on ethics, morals, and science. As research advances, it’s important to weigh these views and explore other paths. This ensures scientific progress without crossing ethical lines.
Embryonic stem cell research raises ethical concerns. This has led to the search for other stem cell sources. Several alternatives have been found, addressing both ethical and scientific challenges.
Induced pluripotent stem cells (iPSCs) come from adult cells that can become many cell types. This breakthrough has changed stem cell research. iPSCs could lead to personalized medicine, making treatments tailored to each patient.
Adult stem cells are found in adult tissues and can turn into specific cells. They help repair and grow tissues. Adult stem cells are safer than embryonic ones because they rarely cause tumors.
Umbilical cord blood stem cells come from the umbilical cord and placenta after birth. They can become different cell types and treat blood disorders. These stem cells are easily available and don’t raise the same ethical issues as embryonic ones.
Exploring these alternatives has opened new paths in stem cell research and therapy. The benefits include:
As research goes on, these alternatives could be key in improving stem cell treatments. They help tackle the issues with embryonic stem cell research.
The world of stem cell research is on the brink of big changes. New technologies and policy shifts are leading the way. We must look ahead to see how these advancements will shape the field.
New tools are being created to improve stem cell research. Some of the most exciting ones include:
As stem cell research grows, rules are likely to change. Some possible updates could be:
Stem cell research faces a big challenge: balancing science with ethics. This means:
By tackling these issues, the field can grow while staying ethical.
The debate on embryonic stem cells has been going on for years. Both sides have strong arguments. The main issue is the moral and ethical questions of using human embryos for research.
Embryonic stem cells could lead to big advances in medicine and new treatments for diseases. But, the idea of destroying human embryos worries many about the value of life and the risk of misuse.
Future research might focus on other stem cell types, like induced pluripotent stem cells. These could solve the ethical problems linked to embryonic stem cells.
The debate on stem cells will likely keep going. We need to find a way to balance scientific progress with ethics. As research moves forward, solving these issues is key to helping everyone.
Embryonic stem cells come from embryos. They can turn into any cell in the body. This makes them important for medical research and possible treatments.
The debate over embryonic stem cell research centers on destroying human embryos. Some see this as morally wrong. There are also worries about treating human life as a commodity and consent issues.
These cells could change regenerative medicine. They might help treat long-term diseases. They also help us understand human development and diseases better.
Embryonic stem cells can become any cell type. Adult stem cells can only become a few types. This makes embryonic stem cells more versatile.
In the U.S., laws about embryonic stem cell research are complex. Federal rules limit funding for research on human embryos. But, some states have their own rules, allowing or banning such research.
iPSCs are made by reprogramming adult cells to be like embryonic stem cells. They offer a way to do research without using embryos, which is appealing to some.
Laws on embryonic stem cell research vary worldwide. Some places, like the U.K. and Australia, are more open. Others, like Germany and Italy, are stricter.
Supporters say this research could lead to big medical wins. They also point out that the embryos used are often from IVF that would be thrown away.
Stem cell research will likely see new tech like iPSCs. Regulations might change too. This will help balance ethics with scientific progress.
Embryonic stem cells come from embryos. They can turn into any cell in the body. This makes them important for medical research and possible treatments.
The debate over embryonic stem cell research centers on destroying human embryos. Some see this as morally wrong. There are also worries about treating human life as a commodity and consent issues.
These cells could change regenerative medicine. They might help treat long-term diseases. They also help us understand human development and diseases better.
Embryonic stem cells can become any cell type. Adult stem cells can only become a few types. This makes embryonic stem cells more versatile.
In the U.S., laws about embryonic stem cell research are complex. Federal rules limit funding for research on human embryos. But, some states have their own rules, allowing or banning such research.
iPSCs are made by reprogramming adult cells to be like embryonic stem cells. They offer a way to do research without using embryos, which is appealing to some.
Laws on embryonic stem cell research vary worldwide. Some places, like the U.K. and Australia, are more open. Others, like Germany and Italy, are stricter.
Supporters say this research could lead to big medical wins. They also point out that the embryos used are often from IVF that would be thrown away.
Critics say destroying embryos is wrong. They suggest using adult stem cells or iPSCs instead. They believe these alternatives are better.
Stem cell research will likely see new tech like iPSCs. Regulations might change too. This will help balance ethics with scientific progress.
Subscribe to our e-newsletter to stay informed about the latest innovations in the world of health and exclusive offers!